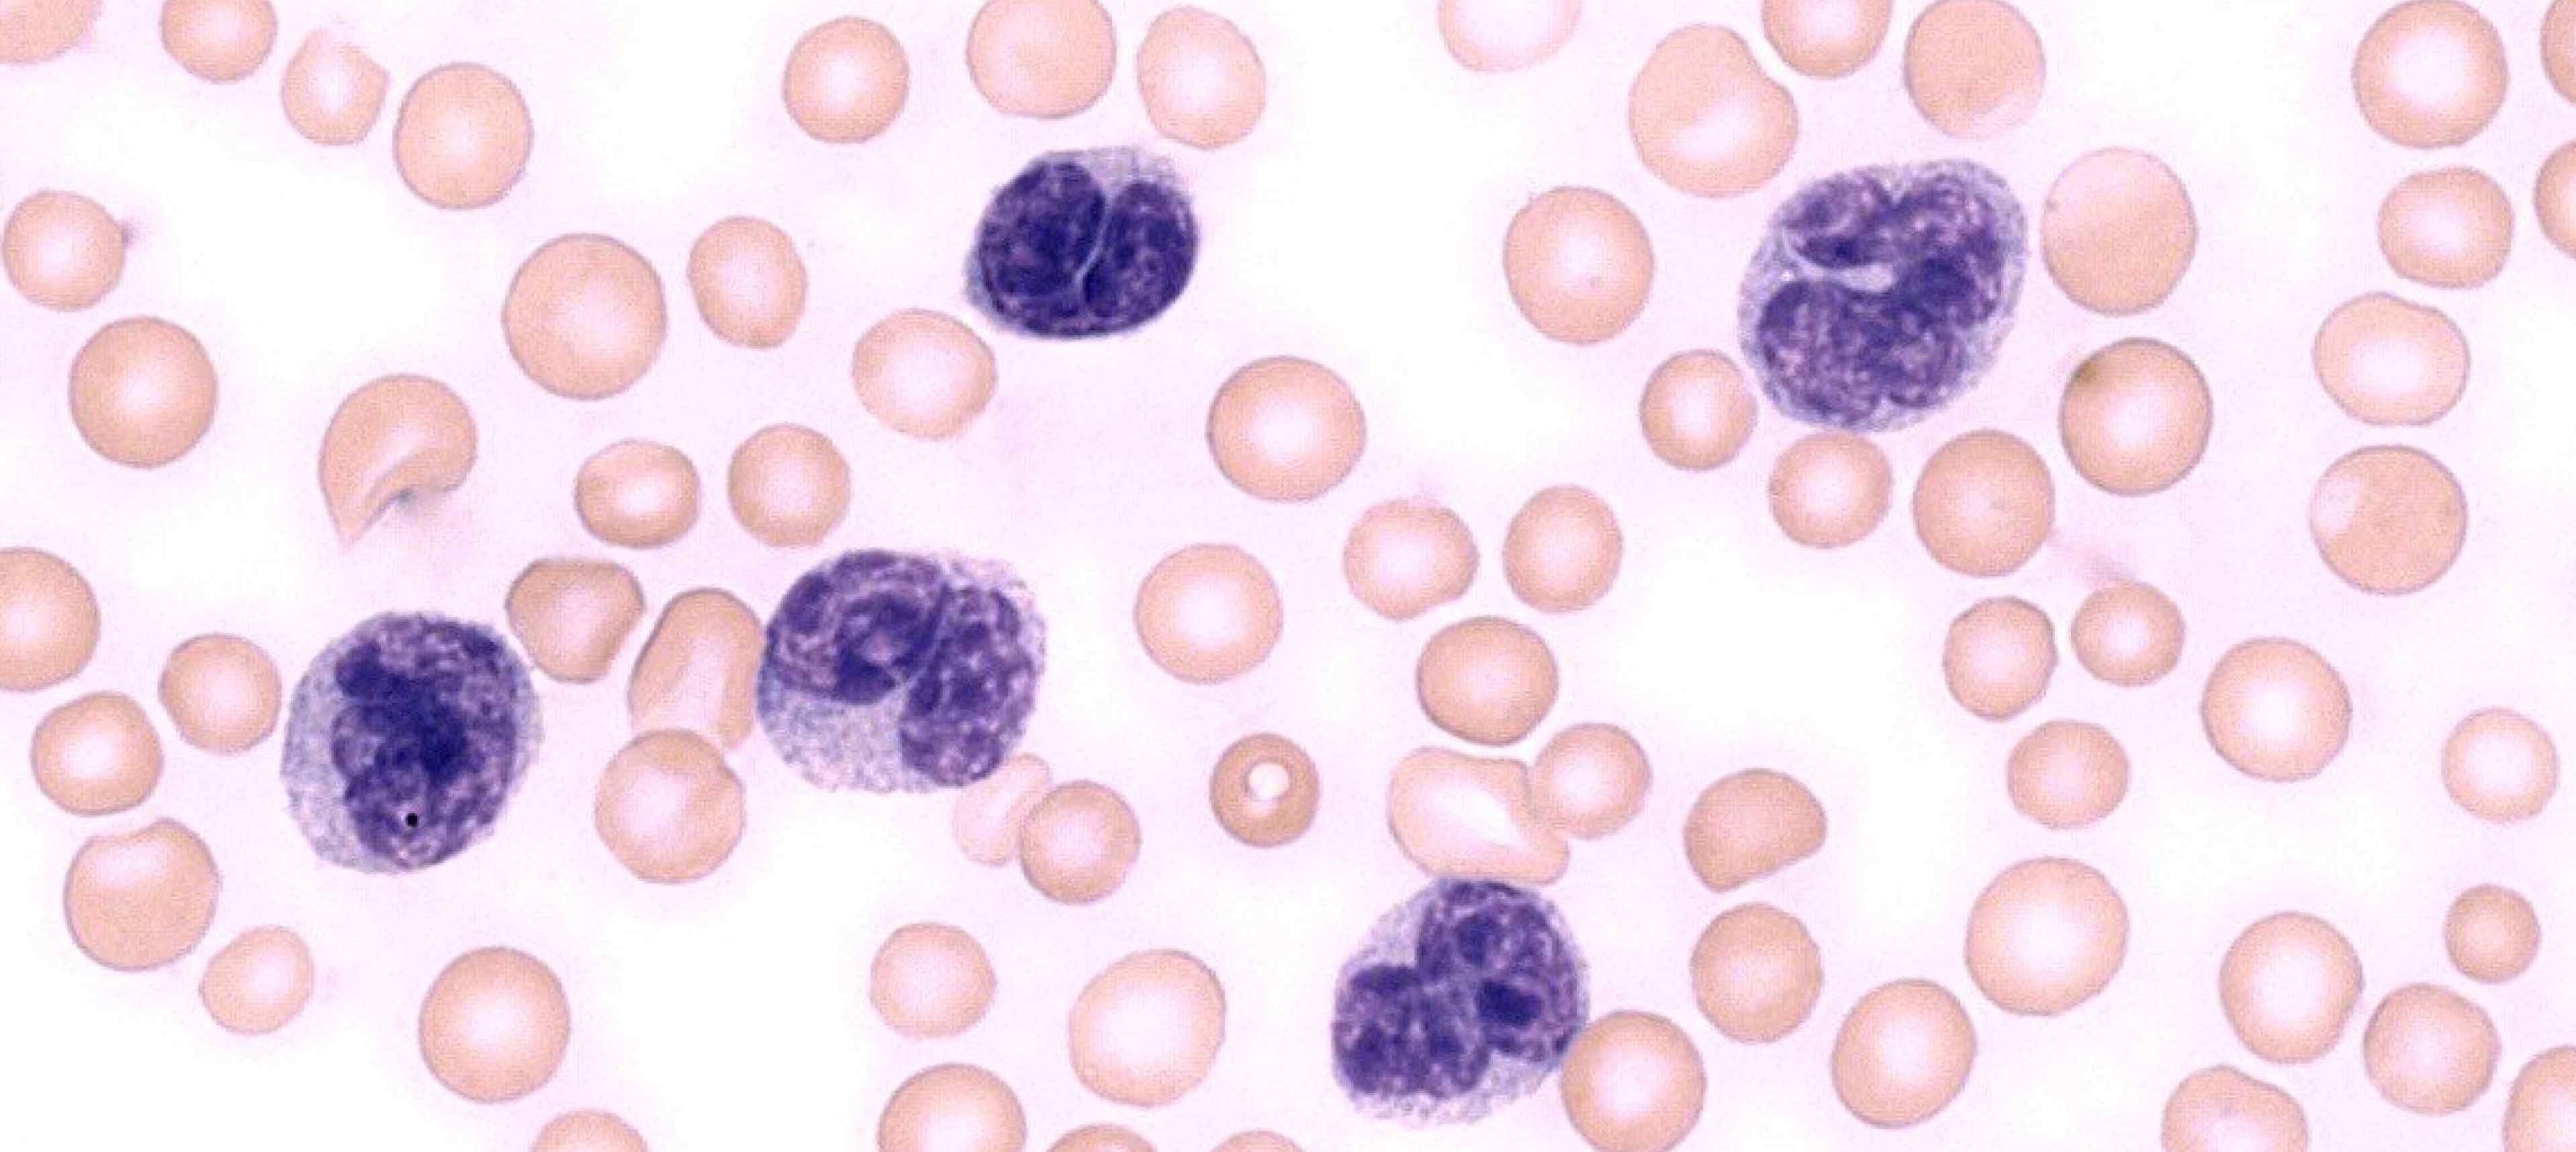
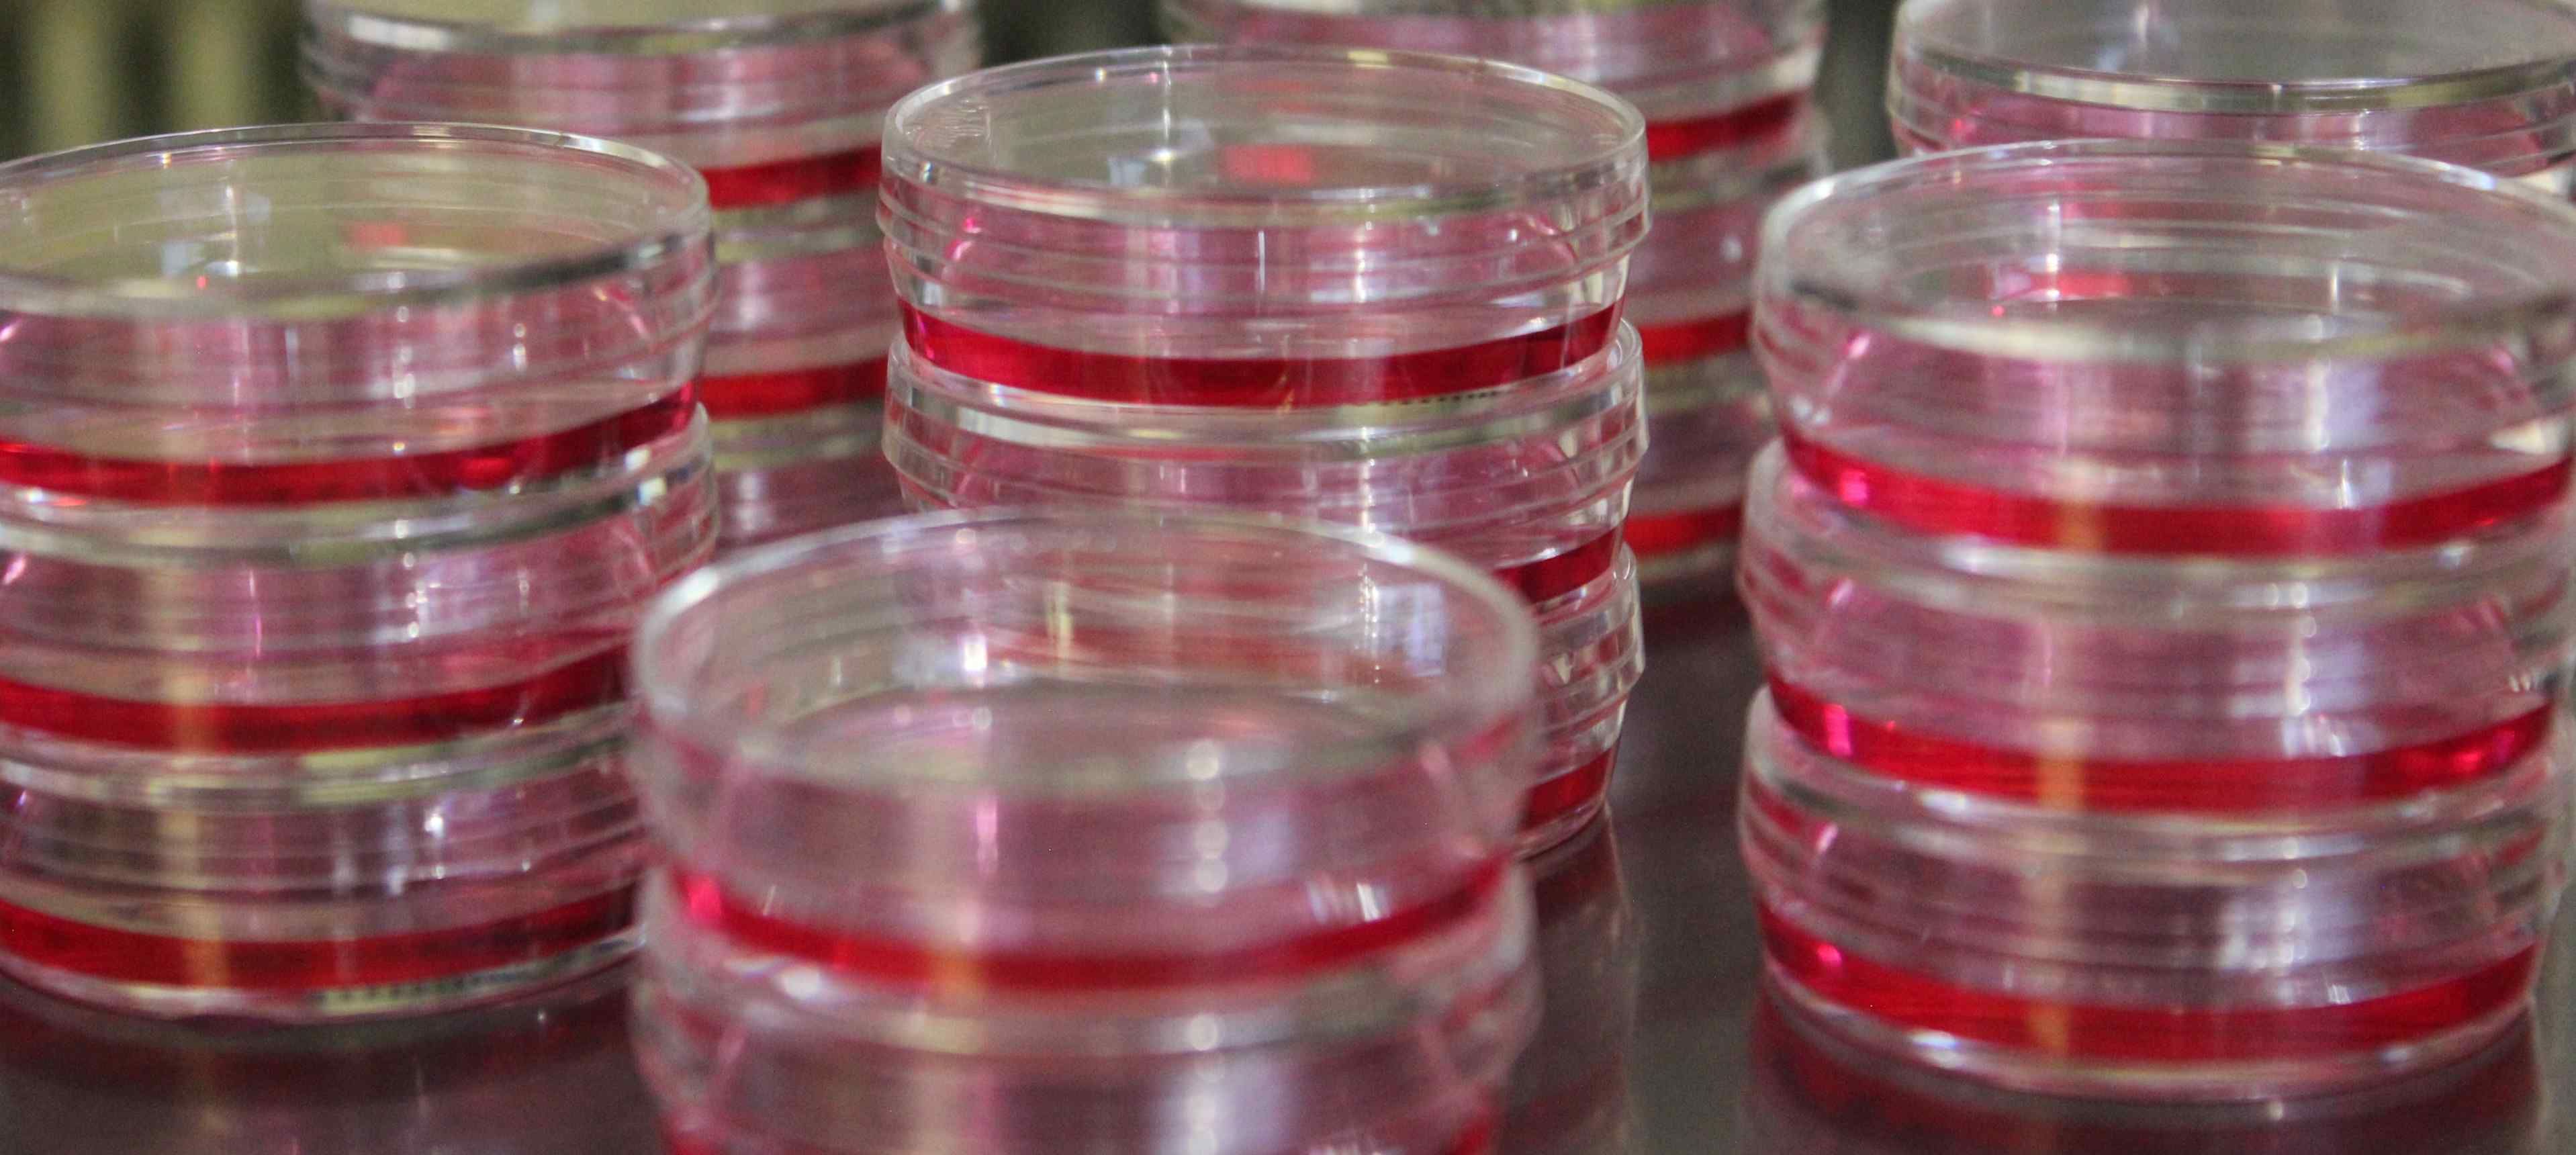

Research
Every day billions of mature blood cells are produced in the bone marrow. Sustained blood production is ensured by an extremely rare population of haematopoietic stem cells (HSC) with self-renewal capacity and the potential to differentiate into all blood cell lineages. A delicate balance between these two processes is essential to maintain blood homeostasis and it’s deregulation is the basis of many blood disorders such as leukaemia.
HSC function is regulated by the surrounding cellular and molecular microenvironment, the so-called niche. The HSC niche is a multi-cellular unit including endothelial cells, mesenchymal stromal cells and mature blood cells. Beyond physical support, these cells provide molecular signals that coordinate HSC survival, proliferation and differentiation. The niche is a dynamic entity, which can remodel in order to respond to specific requirements in blood cell production and maintain homeostasis. However, this remodelling capacity can also be exploited by leukemic cells to generate a malignant microenvironment and thereby contribute to leukaemia development.
We believe that HSC dependency on the niche constitutes a promising avenue for the development of novel therapies for blood regeneration and leukaemia treatment. Yet, the molecular mechanisms involved in these processes are still not well understood.
Our long term goal is to understand the role of the HSC niche in the maintenance of blood cell homeostasis and the development of haematological malignancies by decoding the molecular signals involved in the cross-talk between HSCs and their surrounding environment. To do so we use in vivo models of stress haematopoiesis and leukaemia, which we combine with cutting edge transcriptomics, flow cytometry, bone marrow imaging and single-cell approaches.